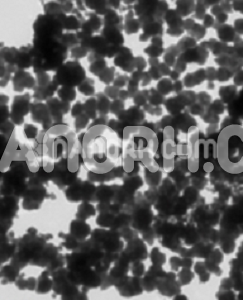

| Fe2O3 Iron Oxide Nanoparticles/Nanopowder Water Dispersion | |
| Product No | NRE-23028 |
| CAS No. | 1309-37-1 |
| Formula | Fe2O3 |
| Molecular Weight | 159.69 g/mol |
| APS | <10nm (can be customized) |
| Purity | 99.9% |
| Color | Brown |
| Density | 5.24 g/cm³ |
| Solvent | Water (as per requirement) |
| pH | 8.0 – 9.60 |
Fe2O3 Iron Oxide Nanoparticles/Nanopowder Water Dispersion